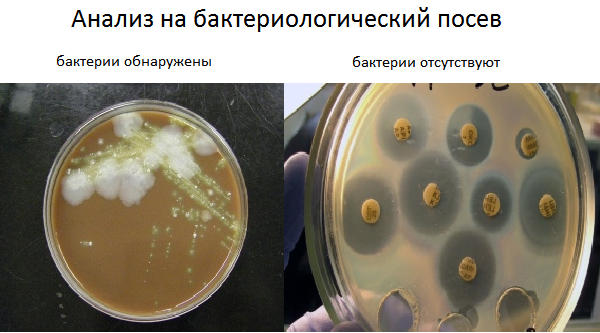

Что такое сдать посев
17 октября день отца видео
Самые древние цитаты
Фрязино до электростали
Самые важные языки в мире
Отзывы хавал новый ф7 реальных владельцев
Договор поставки автомобилей образец
Параллельная парковка куда крутить руль
Katana 17 b12ucr 1024xru драйвера
Номер страниц в эксель при печати
Проект тап
Феодальная теория государства
Ручки для мебели 96 мм
Девочка колючка
Что такое сдать посев 119 фото